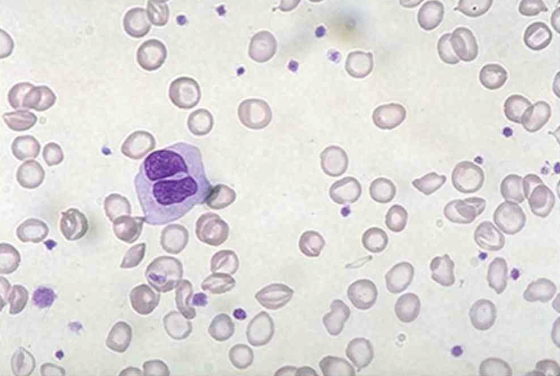

105번
[MD25]
0
65세 남자가 1개월 전부터 쉽게 피로해진다며 병원에 왔다. 5년 전 위암으로 전체위절제술을 받았다. 3개월 전부터 구각염이 지속되고, 1개월 전부터는 운동 시 숨찬 증상이 생겼다고 한다. 혈압 140/80 mmHg, 맥박 78회/분, 호흡 16회/분, 체온 36.5°C 이다. 혈액검사 결과는 다음과 같다. 말초혈액펴바른표본 사진이다. 치료는?
혈색소 7.6 g/dL, 백혈구 4,300/mm3 , 혈소판 178,000/mm3
정답률 54%
누적 풀이 횟수 2,700+
평균 풀이 시간30초
/
나의 풀이 시간0초
CC | M/65, 피로(1m) |
Hx | 5년 전: Gastric cancer s/p total gastrectomy |
S/Sx | 구각염(3m), 운동 시 호흡곤란(1m) V/S 130/80 110 18 37.5 |
Lab | Hb↓ |
Img | |
Etc | PB smear: Microcytic hypochromic RBC |
Imp: 철결핍빈혈(iron deficiency anemia, IDA)
해설
전체위절제술 후 구각염이 동반된 빈혈이며 PB smear에서 central pallor가 큰 microcytic hypochromic RBC가 확인되므로 IDA로 진단한다.
• 65세 남자가 1개월 전부터 지속된 피로를 주호소로 내원하였다.
• 환자는 1개월 전부터 피로와 함께 운동 시 호흡곤란을 호소하므로 anemia임을 감별해야하며 CBC 상 Hb 7.6 g/dL로 감소한 소견을 통해 anemia로 진단한다.
• 환자는 5년 전 위암 진단 후 전체위절제술을 받은 점과 3개월 전부터 지속된 구각염은 IDA를 시사한다.
• PB smear에서 RBC가 백혈구에 비해 많이 작으며 central pallor가 큰 microcytic hypochromic RBC가 확인되므로 IDA로 진단한다.
오답 선지
• 엽산: 결핍 시 macrocytic anemia가 발생하며 알콜중독자, 고령의 환자에서 영양결핍으로 발생한다. 하지만 본 증례는 microcytic hypochromic anemia이다.
• 프레드니솔론: Glucocorticoid 계열 면역억제제로 자가면역 용혈성 빈혈의 치료로 사용된다. IDA의 치료로 사용되지 않는다.
• 사이클로스포린: 면역억제제로 IDA의 치료로 사용되지 않는다.
• 사이아노코발라민: 결핍 시 macrocytic anemia가 발생하며 위절제술 혹은 자가항체로 인한 intrinsic factor의 부족으로 흔히 발생한다. 하지만 본 증례는 microcytic hypochromic anemia이다.
관련 이론
• 철결핍빈혈
Reference
• Harrison 21e, pp.747-752